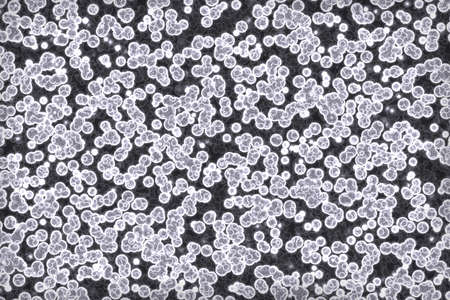
artistic modern many biological cells digital graphic texture illustrationの写真素材

写真素材 - artistic modern many biological cells digital graphic texture illustration
作品情報
artistic modern many biological cells digital graphic texture illustration
- ID:186301951
- 作品種別:写真
- 作者名:Anton Medvedev
キーワード
- abstract
- abstraction
- abstractive
- amount
- backdrop
- bacteria
- bacterias
- bio
- biological
- blank
- bright
- cell
- cells
- colony
- color
- colorful
- computer
- creative
- design
- digital
- dynamic
- elements
- festive
- futuristic
- illustration
- light
- living cells
- lot
- many
- micro
- modern
- monadiform
- monadiforms
- multi colored
- noise
- orgamism
- pattern
- primitive
- shape
- single-celled
- single-celleds
- space
- template
- texture
- unicellular
- virus
- viruses
- vivid
類似作品
Microbiology La...
Backgrounds of ...
Different types...
Achievements of...
Background with...
Achievements of...
Achievements of...
Healthy human r...
Backgrounds of ...
Backgrounds of ...
Mixed of bacter...
Red bubbles of ...
Hands, plant sc...
Motion Color dr...
science medical...
Air bubbles ins...
ink drops
Red bubbles of ...
red coronavirus...
Backgrounds of ...
Backgrounds of ...
Blur foam flow....
Violet macro te...
Rows of microsc...
Backgrounds of ...
Backgrounds of ...
Beautiful psych...
Petri dish with...
Gloved hands of...
In a modern bio...
Rows of microsc...
Bubble flow. Pa...
Handmade modern...
Natural drug re...
Mould aka mold ...
A diverse array...
Backgrounds of ...
Colourful oil i...
Achievements of...
Apple fruit in ...
Backgrounds of ...
Green leaf plan...
Red bubbles of ...
Abstract scienc...
Ink water explo...
Oil drops in th...
Abstract textur...
Beautiful psych...
Backgrounds of ...